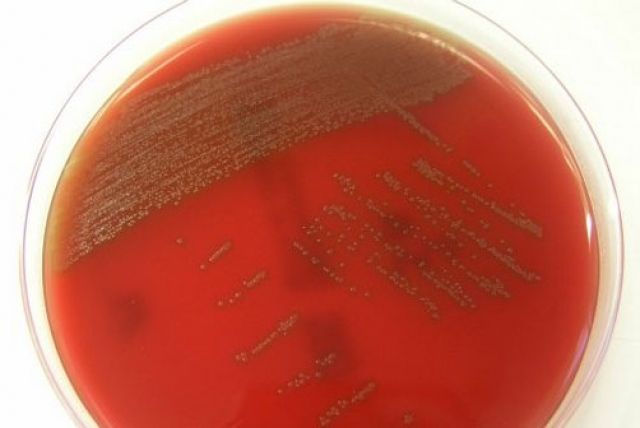
Phát hiện vi khuẩn ở miệng có thể gây bệnh nghiêm trọng

Tổ chức Y tế thế giới (WHO) ngày 23/4 đã công bố các nguyên tắc hướng dẫn mới nhằm nâng cao hiệu quả chống lây nhiễm HIV, đặc biệt đối với các cặp vợ chồng hoặc cặp đối tác có 1 người đã nhiễm HIV.
Các nguyên tắc mới này khuyến khích các cặp đối tác cùng nhau đi xét nghiệm HIV để biết rõ hiện trạng HIV của nhau, đặc biệt là các cặp đã có 1 người nhiễm HIV.
Việc cùng đi xét nghiệm HIV và cùng biết hiện trạng HIV của nhau giúp các cặp đối tác bảo vệ và hỗ trợ nhau tốt hơn trước nguy cơ lây nhiễm virus HIV cũng như cùng đánh giá và lựa chọn các liệu pháp điều trị và ngăn chặn lây truyền HIV từ mẹ sang con. Việc xét nghiệm và tư vấn HIV này hoàn toàn bí mật đồng thời các biện pháp điều trị hoàn toàn trên cơ sở tự nguyện không cưỡng bức. Các nguyên tắc này cũng đề xuất liệu pháp chống lây nhiễm vi rút cho người đã nhiễm HIV để đối tác của họ tránh được lây nhiễm.
Tổng Giám đốc Chương trình chung của LHQ về HIV/AIDS (UNAIDS), Michel Sidibé, nhấn mạnh, các cặp đối tác hoặc vợ chồng có thể tận dụng lợi ích của liệu pháp chống virus này để cải thiện sức khoẻ và bảo vệ đối tác của mình. Thông qua việc khuyến khích cùng đi xét nghiệm HIV, các cặp này sẽ được cung cấp các lựa chọn ngăn chặn và điều trị để họ có thể cùng thảo luận và cùng xử lý hiện trạng.
Liệu pháp cho cặp đối tác đã có 1 người nhiễm HIV đã có hiệu quả cao làm giảm nguy cơ lây HIV từ người đã bị nhiễm HIV sang bạn tình của họ, đồng thời cho phép quan hệ tình dục bình thường nếu họ sử dụng các biện pháp tình dục an toàn. Với liệu pháp này, hàng triệu nam nữ trên thế giới có được một lựa chọn mới bổ sung để ngăn chặn các ca lây nhiễm HIV mới.
Theo chinhphu.vn